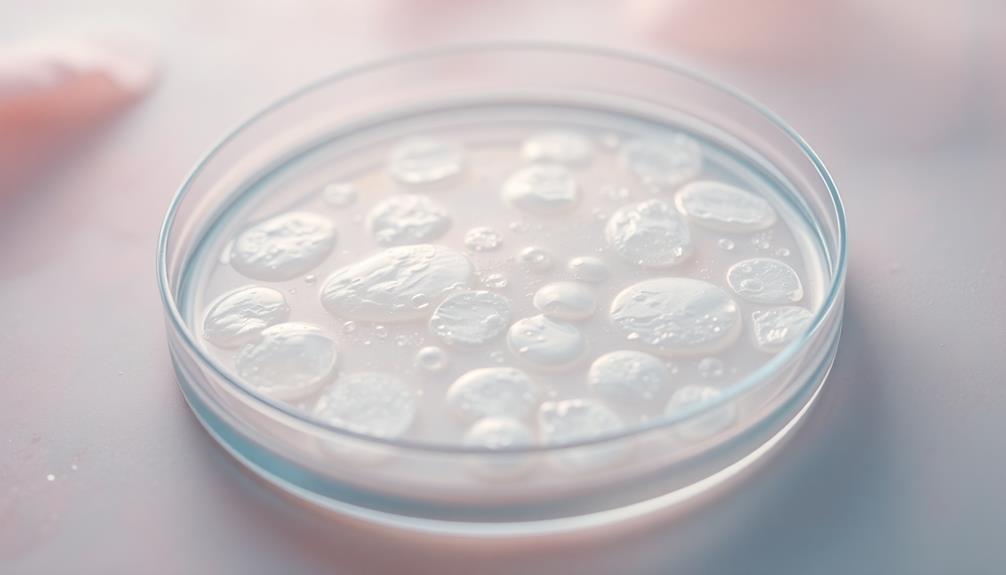

Early pregnancy discharge usually has a unique smell that's often described as slightly musky or earthy. This scent happens because your body's hormones, especially estrogen, are changing to support your pregnancy. Many women notice a thicker, creamier discharge too. Sometimes, the smell might seem metallic or more pronounced during physical activity. However, if you catch an unusual or foul odor, that could mean it's time to check in with a doctor. Remember, every experience is different, and understanding your body makes it less confusing. Keep exploring to discover more about what these changes can mean!
Key Takeaways
- Early pregnancy discharge often has a slightly musky or earthy smell, influenced by hormonal changes in the body.
- Some women may notice a metallic or iron-like scent during early pregnancy discharge.
- Normal discharge typically has a light, sweet smell and is usually clear or milky in appearance.
- Unusual or foul smells, especially if accompanied by color changes or itching, may indicate infections and should prompt a doctor's visit.
- Physical activity and tight clothing can amplify the perception of discharge odor due to increased blood flow and moisture retention.
Introduction

When you're early in your pregnancy, you might notice changes in your body, including your discharge. This is completely normal and often happens as your body adjusts to the wonderful journey ahead.
Discharge is your body's way of keeping the vagina clean and healthy, and in pregnancy, it's usually more noticeable. You may see an increase in the amount of discharge, and it might change in color and consistency.
As hormones start to flow through your system, especially estrogen, you might find that the discharge becomes thicker and creamier. It's your body's way of preparing for all the changes that come with carrying a baby.
Although it can be surprising, it's generally a sign that your body is doing what it needs to do.
Description of the Smell

As pregnancy progresses, you might pick up on a distinct smell associated with your discharge. This smell can vary quite a bit, but many women describe it as slightly musky or earthy.
You might notice it more when you're sweating or if you've recently been active. It's not usually super strong, but it's definitely there, reminding you that your body is going through incredible changes.
Some women even say it smells a bit like metal or iron, which can be surprising.
Don't worry; this is all part of the fun and adventure of pregnancy! If you notice a change in the smell that's particularly foul or different from what's normal for you, it's always a good idea to check in with your doctor.
They can help you figure out if it's just a normal part of pregnancy or something that needs a little more attention.
Source and Composition
The source of early pregnancy discharge primarily stems from hormonal changes in your body. When you become pregnant, your hormone levels, especially estrogen and progesterone, rise significantly. These hormones help prepare your body for the growing baby and also affect your vaginal environment.
You might notice increased blood flow to your pelvic area, which can lead to more discharge than usual. The composition of this discharge varies, but it typically includes a mix of cervical mucus, vaginal fluids, and other secretions. It's generally clear or milky and has a light, slightly sweet smell.
This is normal and indicates that your body is doing what it needs to support the pregnancy. It's important to remember that everyone's body is different, so your discharge may vary in amount and consistency.
If you notice any unusual changes, like a strong odor or color, you should definitely talk to a healthcare professional. They can help you figure out what's going on.
Typical Scenarios or Environments

Understanding typical scenarios or environments where you might notice early pregnancy discharge can help you feel more at ease. You may find this discharge more noticeable during certain times of the day or in specific situations.
For instance, many women notice it more when they wake up in the morning or after a long day at work. This is because your body naturally produces more cervical fluid during sleep and after periods of inactivity.
You might also experience changes during physical activities, like exercising or engaging in intimate moments. Increased blood flow and hormonal changes can lead to a bit more discharge, which is totally normal.
Additionally, if you're wearing tight clothing or certain materials, that can affect how you perceive the discharge's smell. Synthetic fabrics can trap moisture, amplifying any odors, while breathable fabrics allow moisture to escape.
Emotional or Cultural Associations

Discharge during early pregnancy often carries a mix of emotional and cultural associations that can impact how you perceive it. You might feel excitement, anxiety, or even confusion as your body goes through changes. It's normal to have a rollercoaster of emotions, especially if you're trying to understand what your body is telling you.
In many cultures, pregnancy is celebrated, and certain symptoms, like discharge, might be seen as a sign of good news. You might hear stories from friends or family about their experiences, which can shape how you feel about your own situation.
Some cultures emphasize the importance of staying calm and relaxed during pregnancy, so if you notice changes, it's helpful to talk about them openly.
Health or Safety Considerations

During early pregnancy, paying attention to any changes in discharge is crucial for your health and safety. Discharge can vary in color, consistency, and smell, and these changes can signal important information about your body. Typically, early pregnancy discharge is clear or milky white and has a mild scent.
If you notice a strong, foul smell, it could indicate an infection, which might need a doctor's attention.
It's essential to monitor any changes in your discharge closely. If it becomes yellow or green, or if you experience itching or burning, don't hesitate to reach out to a healthcare professional. They can help determine if there's a problem and guide you on the best treatment. Remember, it's always better to be safe than sorry!
Staying hydrated and maintaining good hygiene can also support your health during this time.
And while it might feel awkward, discussing your symptoms with a trusted friend or healthcare provider can be incredibly beneficial. You're not alone in this journey!
Final Thoughts

It's important to remember that every pregnancy is unique, and being attuned to your body's signals can make a significant difference in your experience.
When it comes to early pregnancy discharge, knowing what's normal is key. You might notice changes in color, consistency, and even smell. Don't worry; this is your body adjusting to the new adventure ahead.
If you detect a smell that's unusual or unpleasant, it might be your body's way of signaling a potential issue. Sure, some variations are perfectly normal, but trusting your instincts is crucial.
If something feels off, don't hesitate to reach out to a healthcare professional. They're there to help you understand what's happening and provide reassurance.
Frequently Asked Questions
Can Early Pregnancy Discharge Vary in Smell Throughout the Day?
Yes, early pregnancy discharge can vary in smell throughout the day. Factors like diet, hydration, and hormonal changes influence it. You might notice different scents at different times, so pay attention to those shifts.
What Factors Can Influence the Smell of Early Pregnancy Discharge?
Several factors can influence the smell of early pregnancy discharge, including hormonal changes, diet, hydration levels, and any underlying infections. Staying aware of these factors can help you better understand your body's signals during this time.
Is It Normal for Discharge to Have No Smell at All?
Yes, it's normal for discharge to have no smell at all. Every woman's body is different, so you might notice variations. As long as there are no other concerning symptoms, it's usually nothing to worry about.
How Does Early Pregnancy Discharge Differ From Menstrual Discharge?
Early pregnancy discharge often appears thinner and more consistent compared to menstrual discharge, which can be thicker and vary throughout your cycle. You might notice a change in color or texture during early pregnancy.
Can Diet Affect the Smell of Early Pregnancy Discharge?
Yes, your diet can affect the smell of early pregnancy discharge. Foods like garlic or onions may cause stronger odors, while a balanced diet can help maintain a neutral scent. Staying hydrated also plays a role.